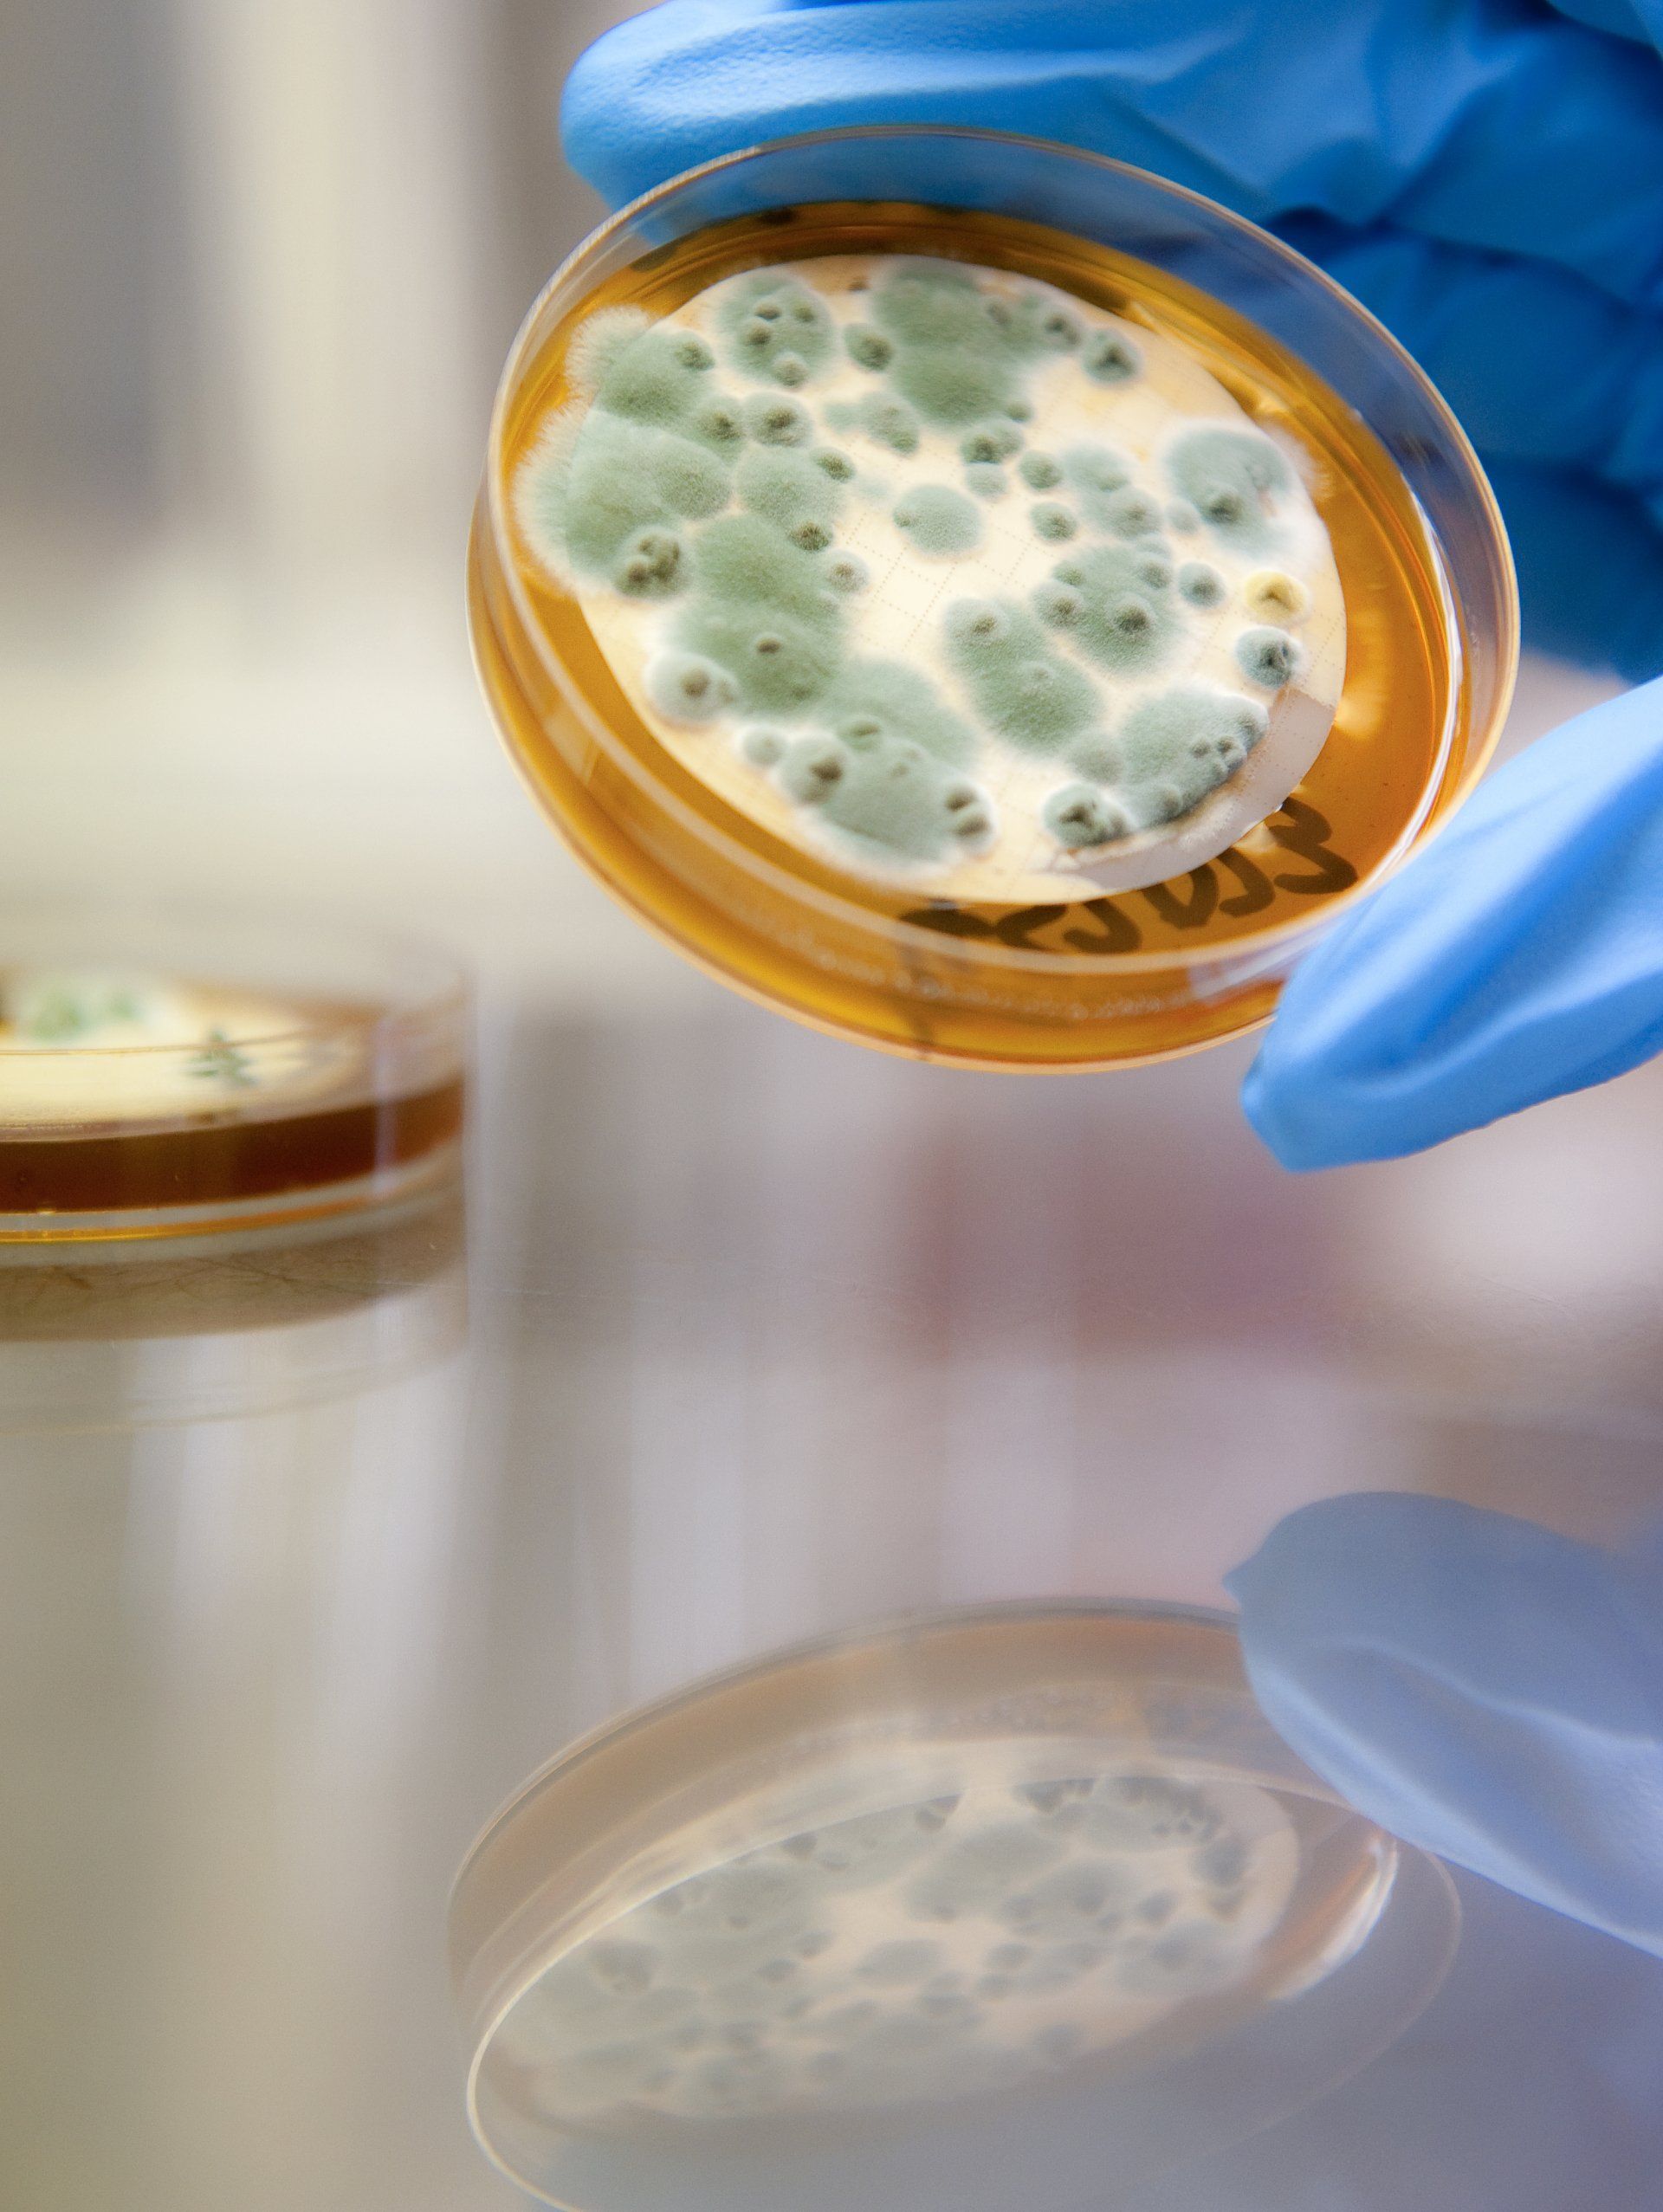
IPL Diesel Bug Analysis Video

Videos
Dedicated to providing quality lab testing services
About IPL
Established in July 1999, Independent Petroleum Laboratory Limited (IPL) is a fully independent laboratory that provides specialist Fuels, Biofuels, Industrial and Environmental laboratory testing services to a wide range of customers throughout New Zealand and the South West Pacific.
Get the latest information and promotions in your inbox
Newsletter
Thank you for contacting us.
We will get back to you as soon as possible.
We will get back to you as soon as possible.
Oops, there was an error sending your message.
Please try again later.
Please try again later.
© 2026
IPL : Website Design Auckland by Fuel Design Ltd